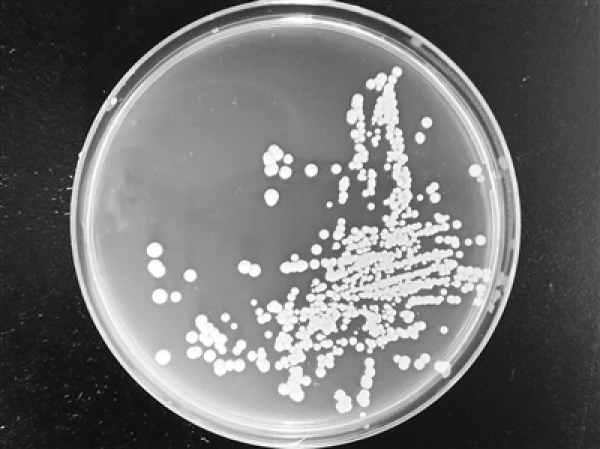
The Pichia pastoris yeast, engineered for superior methanol tolerance and conversion efficiency

Chinese scientists have developed a cost-effective method of converting coal into protein, which they say could feed livestock much more efficiently than natural plants, while using a tiny fraction of the land.
According to Our World in Data, grazing land for livestock and farming land for animal feed production combine to take up an astonishing 40 million square kilometers (15.4 million square miles) of land. That's well over a quarter of the Earth's entire dry land area, and nearly 40% of the land defined as "habitable."
This is one of the reasons the meat-heavy Western diet is under fire as environmentally unsustainable; growing plants to feed animals makes wretchedly inefficient use of land, which could otherwise be left as forest or used for other purposes.

One solution is moving toward lab-grown meat – but another may be to start producing protein for livestock feed using other methods. This would be a particular boon to China. According to Biotech researchers at the Chinese Academy of Sciences (CAS), the country is currently forced to import around 80% of its protein raw materials in the form of soybeans and the like – and that's a serious food security issue for the nation.
So the team set about research into processes that could use fossil fuels to produce proteins, building on oil-to-protein biotechnology pioneered by BP as far back as the 1960s.
The CAS team's process works something like this: firstly, coal is transformed into methanol via gasification – a technique that can now be executed with near-zero carbon emissions. That methanol is then fed to a special strain of Pichia pastoris yeast, which ferments the methanol to produce a single-cell protein complete with a range of amino acids, vitamins, inorganic salts, fats and carbohydrates. The resulting organism is much richer in protein than plants are, and it can be used to partially replace fish, soybeans, meat and skimmed milk in a range of animal feeds.
The team's key innovation was in selecting and genetically engineering the yeast strain, making it more able to tolerate the toxic effects of methanol than previous strains in order to maximize conversion efficiency and minimize the amount of carbon lost during the process.
The result: a yeast that converts methanol into protein at a remarkable 92% of the maximum theoretical yield of the process. That, says the team, makes it "a cost-effective option for the industrial production of protein."
According to the South China Morning Post, the researchers have already hooked up with an undisclosed manufacturing partner to start industrial-scale demonstrations that have already produced "thousands of tonnes of this protein in a plant."
The research is open access in the journal Biotechnology for Biofuels.
Source: SCMP via Interesting Engineering